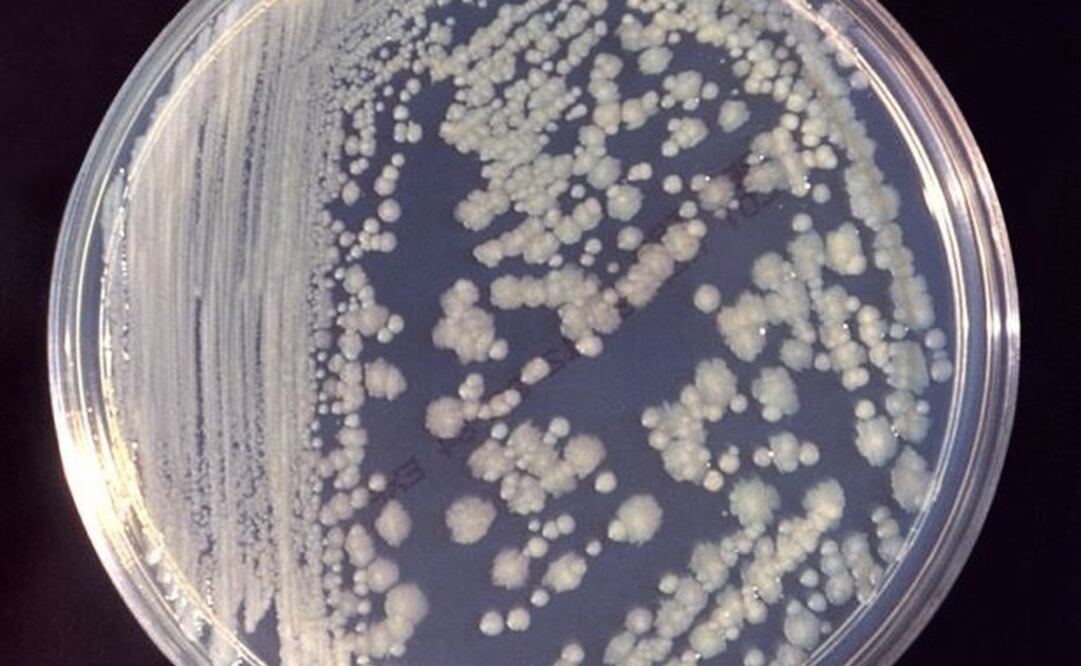
Las bacterias de la Estación Espacial pueden sobrevivir al espacio. Foto: DPA

[Publicidad]
Los microbios localizados en la Estación Espacial Internacional (ISS) solo están tratando de sobrevivir y no de hacerse peligrosos para la salud de los astronautas a través de sus mutaciones.
Un nuevo estudio de la Universidad Northwestern ha encontrado que, a pesar de sus condiciones aparentemente difíciles, el complejo orbital no está haciendo que las bacterias muten en superbacterias peligrosas y resistentes a los antibióticos.
Aunque el equipo descubrió que las bacterias aisladas de la estación contenían genes diferentes a sus contrapartes terrícolas, esos genes no hicieron que las bacterias fueran más perjudiciales para la salud humana. En cambio, las bacterias simplemente responden, y tal vez evolucionan, para sobrevivir en un ambiente estresante, tal y como se detalla en un artículo publicado en la revista 'mSystems'.
"Se ha especulado mucho acerca de la radiación, la microgravedad y la falta de ventilación, y cómo eso podría afectar a los organismos vivos, incluidas las bacterias -señala la directora del estudio, Erica Hartmann-. Son condiciones estresantes y duras. ¿Selecciona el entorno a las superbacterias porque tienen una ventaja? La respuesta parece ser 'no".
A medida que los preparativos sobre el envío de viajeros a Marte se vuelven más serios, ha habido un creciente interés en comprender cómo se comportan los microbios en ambientes cerrados. "La gente estará en pequeñas cápsulas donde no pueden abrir ventanas, salir al exterior o hacer circular el aire durante largos periodos de tiempo --apunta en un comunicado Hartmann, que es profesora asistente de Ingeniería Ambiental en la escuela de Ingeniería McCormick de la Universidad Northwestern--. Estamos realmente preocupados por cómo podría afectar esto a los microbios".
La ISS alberga miles de microbios diferentes, que han viajado al espacio en astronautas o en la carga. El Centro Nacional de Información Biotecnológica mantiene una base de datos disponible públicamente, que contiene los análisis genómicos de muchas de las bacterias aisladas de la ISS. El equipo de Hartmann utilizó esos datos para comparar las cepas de 'Staphylococcus aureus' y 'Bacillus cereus' en la ISS con las de la Tierra.
[Publicidad]
Más información

Metrópoli
Clara Brugada felicita al Cruz Azul por el campeonato de la Liga MX; reconoce esfuerzo de Pumas

Universal Deportes
Así reaccionó Efraín Juárez al gol de Rotondi que le dio el título a Cruz Azul: "Vale ve... Se acabó"

Universal Deportes
Joel Huiqui y los escasos partidos que necesitó para salir campeón con Cruz Azul

Universal Deportes
Cruz Azul es campeón, pero ni así se salvaron de los MEMES en las redes sociales